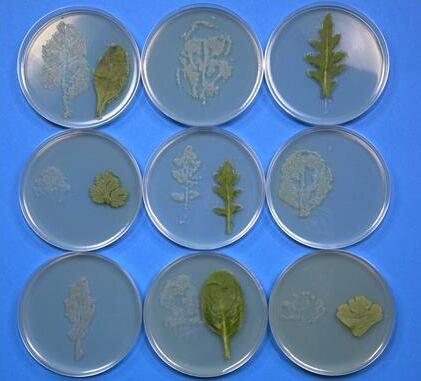

University of Leicester microbiologists found juices released from damaged leaves also enhanced the virulence of the pathogen, potentially increasing ability to cause infection in the consumer.
They showed juices released from the cut-ends of the salad leaves enabled Salmonella to grow in water, even when it was refrigerated.
Salad juice exposure also helped the Salmonella cells to attach to the salad leaves so strongly that washing could not remove them and the presence of existing leaf microbiota does not prevent pathogen attachment.
Salmonella growth by end of shelf life
The research was led by Dr Primrose Freestone of the University’s Department of Infection, Immunity and Inflammation and PhD student Giannis Koukkidis, funded by a Biotechnology and Biological Sciences Research Council (BBSRC) i-case Studentship.
Dr Freestone said a few Salmonella cells in a salad bag at the time of purchase could become many thousands by the time it reaches its use by date even if kept refrigerated.
“Salad leaves are cut during harvesting and we found that even microliters of the juices (less than 1/200th of a teaspoon) which leach from the cut-ends of the leaves enabled Salmonella to grow in water, even when it was refrigerated.
“These juices also helped the Salmonella to attach itself to the salad leaves so strongly that vigorous washing could not remove the bacteria, and even enabled the pathogen to attach to the salad bag container.”
The work did not look for evidence of Salmonella in bagged salads but examined how it grows on salad leaves when they are damaged.
Practices to reduce pathogen growth in fresh salad produce include refrigeration after harvesting, rapid processing and packaging under a modified atmosphere containing reduced oxygen levels.
Giannis said: "Anything which enhances adherence of foodborne pathogens to leaf surfaces also increases their persistence and ability to resist removal, such as during salad washing procedures.
“Even more worrying for those who might eat a Salmonella contaminated salad was the finding that proteins required for the virulence of the bacteria were increased when the Salmonella came into contact with the salad leaf juices.”
Expert reaction: Temperature and packaging issues
Dr Jeri Barak, associate professor of Plant Pathology at the Food Research Institute, University of Wisconsin-Madison, said none of the experiments mention using modified atmosphere packaging or a low-oxygen environment.
“It’s therefore unlikely that the experiments are reflective of the environment experienced by Salmonella before a consumer opens the bag.”
Dr Barak said ‘salad juice’ would be an addition of carbon and nitrogen (extra food for Salmonella) to the medium giving it more growth capacity in the one treatment over the other.
“To determine the role of salad juice, equivalent concentrations of carbon and nitrogen found in the salad juice should be added to the ‘control medium’ or controlled for any additional growth observed due to the differences in the two media.”
Martin Adams, Emeritus professor of Food Microbiology at the University of Surrey, said much of the work was at an unspecified room temperature rather than at chill temperatures.
“What did concern me was the report that the particular strain of Salmonella used in the work was able to grow at 4oC – refrigeration temperature. The generally accepted view of a number of national and international bodies is that most Salmonellas do not grow below about 7oC and several national food safety agencies specify an absolute minimum growth temperature for Salmonella of 5.2oC.”
Dr Nicola Holden from The James Hutton Institute said: “One of the biggest issues with the work is temperature - many of the experiments were carried out at room temperature and assessed after 24 hours, which is not necessarily relevant to real world situations for how bagged salad is stored and used.”
Source: Applied and Environmental Microbiology
“Salad leaf juices enhance Salmonella growth, fresh produce colonisation and virulence”
Authors: Giannis Koukkidis, Richard Haigh, Natalie Allcock, Suzanne Jordan and Primrose Freestone